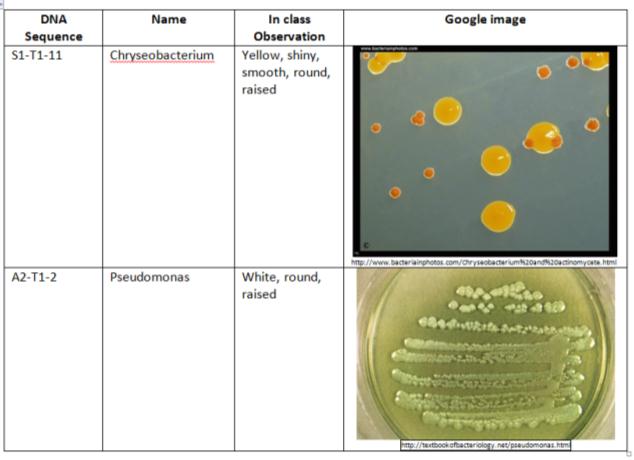

User:Cara Pearson/Notebook/Biology 210 at AU
3/22/2014
Embryology Lab: The effect of Retinoic Acid on zebrafish embryo development
Introduction/Purpose
The purpose of this lab is to learn the stages of embryonic development by comparing embryonic development in different environmental conditions. This study will test the effects of Retinoic Acid (vitamin A) on the embryotic development of zebra fish. The zebrafish is a popular model for the study of vertebrate development, because the embryos and adults are small, transparent and develop quickly. In a previous study, “Teratogenic Effects of Retinoic Acid and Related Substances on the Early Development of the Zebrafish as Assessed by a Novel Scoring System”, scientist noticed that zebrafish exposed to higher levels of Retinoic Acid exhibited underdeveloped heart growth, bent shorter tails, delayed hatching, sessile embryos, and deformities in brain development. If exposing zebrafish to levels of Retinoic Acid, it is predicted that the fish will be underdeveloped and shorter than the control fish, as well as exhibit a lower heart rate due to underdeveloped heart. It is also predicted that there will be no effects on pigmentation, and eye development.
Methods
Part I: Hatching Zebrafish
1. Obtain 2 petri dishes, one labeled “Control”, one labeled “Vitamin A”
2. Add 20 mL of Deer Park water to the control dish
3. Add 20 mL of Retinoic Acid (vitamin A)
4. Add 20 healthy translucent embryos to each dish and allow dishes to sit until further observations
5. Feed two drops of paramecium starting after one week.
Part II: Observing Zebrafish development
1. in 2-4 day increments observe and document hatching, viability, pigmentation, heart-rate, structure, fin and eye development, etc
a. Measure heart rate under compound microscope counting the heartbeats in 15 seconds then multiplying by 4
2. Remove dead zebrafish and egg casings if present and place dead fish in paraformaldehyde
3. Remove 10 mL of water and Vitamin A solution from respective dishes and replace with fresh 10 mL
Part III: Fixing Zebrafish for Observation Under Dissecting Microscope
1. Pipette 3 zebrafish to 0.02% Tricaine solution
2. Transfer the zebrafish 3 anesthetized dead zebrafish to a 4% formaldehyde solution
Raw Data
Table 1: Shows the embryonic development of Zebrafish over a two week period for a test group.
Table 2: Shows the embryonic development of Zebrafish over a two week period for a control group exposed to Retinoic Acid.
After observing zebra fish exposed to Retinoic Acid for two weeks compared to a control group, it was observed that the fish experienced delayed hatching, and darker pigmentation. It was also observed that the fish did not live as long after hatching. The fish exhibited similar growth to the control fish, and movement remained consistent as well. Eye diameter was smaller for the fish in the test group at 250 um compared to 350 um.
Discussion
In a previous study, “Teratogenic Effects of Retinoic Acid and Related Substances on the Early Development of the Zebrafish as Assessed by a Novel Scoring System”, scientist noticed that zebrafish exposed to higher levels of Retinoic Acid exhibited underdeveloped heart growth, bent shorter tails, delayed hatching, sessile embryos, and deformities in brain development. This study encountered some similar results such as delayed hatching, however, after studying the effects of Retinoic Acid on zebrafish for two weeks, we encountered mostly different results. The major differences observed in this lab were thickness and color of the fish. In this experiment, the zebrafish exposed to Retinoic Acid were thinner than the zebrafish in the control. The Retinoic Acid fish were also a brighter shade of yellow than the control fish. This is an interesting observation because it contradicts pigmentation observations in the “Teratogenic Effects of Retinoic Acid and Related Substances on the Early Development of the Zebrafish as Assessed by a Novel Scoring System” study which exhibited no differece. Other data that contradicted the prior study’s observations was that we did not observe stunted or bent tail growth, or sessile embryos. We noticed a smaller eye diameter in zebra fish exposed to Retinoic Acidbut, unfortunately, it was not possible to observe heart and brain development, but we did notice a lower hear rate in the test fish. In conclusion, zebrafish embryology development is affected by exposure to Retinoic Acid by way of pigmentation, heart rate, and hatching. In future studies it would be interesting to observe the effects of Retinoic Acid on the inside orangs of the zebra fish rather than just outer characteristics.
CMP
3/16/2014
Bacteria Sequencing
Introduction/Purpose
In Lab 3 PCR was done on bacteria from the transect that was grown on agar plates in order to sequence the bacterial DNA. The purpose of this lab was to use this DNA sequences to identify the kind of bacteria present and cultured on the marshy transect. By identifying the bacteria based off of DNA sequences, it will be possible to compare in lab observations with common knowledge of the bacteria.
Methods
1. In separate tubes, transfer two colonies to 100 uL of water in a sterile tube
2. Incubate at 100oC for 10 minutes
3. Centrifuge
4. Add 5 uL to PRC tube and incubate
5. Purify PCR products using a Qiagen kit
6. Send PCR products to Genewiz Inc. for sequencing
7. Use NCBI Blast to identify DNA sequence
Raw Data
Conclusions
This lab proved that there are multiple different kinds of bacteria coexisting on the small plot on American University's campus. It is important to note that the bacteria sequences used in this lab were collected by another section studying the marshy transect as the PCR done for this transect in section 6 was not sent for sequencing because there was not adequate PCR product.
CMP
2/28/14
Lab 5
Introduction/Purpose
There are 14 different phyla of invertebrates known today. Within each phyla there are millions of species of invertebrates that have been studied. Invertebrates can have bilateral symmetry, head tail right versus left side, formed by ectoderm (skin and nervous system), endoderm (lining of digestive tract), and mesoderm (muscle, circulatory system, organs, and bones). The purpose of this lab is to understand the importance of invertebrates and to study simple invertebrate systems which have evolved into more complex systems to create the many species of invertebrates known today. It is predicted that the Berlese Funnel sample will yield many invertebrate species to observe due to the human interaction, vertebrate interaction, and the natural erosion that occurs on the transect.
Materials/Methods
Part I: Observing Acoelomates, Pseudocoelomates, and Coelomates
1. Observe acoelomates, Planaria under the dissecting microscope
2. Observe acoelomates, Planaria cross sectional slide under the microscope
3. Observe nematodes and a cross sectional slide of pseudocelomate structure
4. Observe coelomate, Annelida, internal organs and muscle layers
Part II: Analyzing Invertebrates Collected with Berlese Funnel
1. Transfer the preservative solution from Berlese Funnel to petri dish
2. Examine preservative under dissecting microscope
3. Use dichrotomous key to identify 5 organisms in the petri dish
Part III: Vertebrates and Niches
1. Identify five vertebrates, as they appears in textbook, that may inhabit transect
2. Determine classification of each vertebrate
3. Describe which biotic and abiotic factors of transect would benefit vertebrates
4. Construct food web based off of organisms found on transect
Raw Data
Part I: Observing Acoelomates, Pseudocoelomates, and Coelomates
Figure 1: Depicts the structure of Acoelomates, Pseudocoelomates, and Coelomates
Part II: Analyzing Invertebrates Collected with Berlese Funnel
Figure 2: Shows invertebrates from West Virginia. The only invertebrate found in the Berlese Funnel sample from the transect was the fly
Part III: Vertebrates and Niches
Figure 3:Shows 5 vertebrates that might inhabit the transect
Conclusions
Based off of the raw data collected and the observations of the Berlese Funnel sample under the dissecting microscope, there are little to no invertebrates living near the surface and in decomposing leaves on the transect. It is important to note, however, the Berlese Funnel method depends on heat and the disassociation of the dirt to force organisms down through the leaf litter. It is possible that many of the worms or insects are not captured due to drying up and not passing through the leaf litter. It is also possible that larger invertebrates like centipedes, ants, spiders etc, could not fit through the screen to pass into the preservative. It is likely that there are more invertebrates living on the transect beside the one fly we found, thus the Berlese Funnel sample is rendered inconclusive. Because of the expected amounts of invertebrates present on the transect, it is likely they attract vertebrates like birds and land animals that eat bugs. In future studies it would be interesting to observe animal interaction with the transect through video recording or visual stakeout, as there are invertebrates, green plants, and seeds viable to sustain animal nourishment.
Figure 4: Shows a predicted food web's trophic relationship on the American University 20 ft x 20 ft transect
CMP
2/28/14
Lab 4
Introduction/Purpose
Plants and fungus are major contributors to the hospitable atmosphere in the symbiotic environment on the planet. Fungus releases carbon dioxide into the atmosphere and nitrogen into the soil which is used as nutrition by green plants. In addition to being a natural food source for animals, green plants absorb carbon dioxide and release oxygen into the atmosphere which is an import byproduct for our survival. Without plants, the earth could have remained an inhospitable environment. Over the last millions of years, plant evolution has grown to provide us with the wide variety of plants that can be found today. It is commonly agreed that land plants evolved from aquatic green algae, earliest likely being the Bryophytes. Bryophytes consist of mosses which are nonvascular plants. As plants began to specialize, Tracheophytes evolved from the Bryophytes in a process called radiation. Radiation is the rapid explosion of new species, in a new environment, from a common ancestor. With radiation, the Tracheophytes developed vascularization. Having a vascular system evolved new ways to reproduce by way of developing seeds. Seeds caused a new radiation that led to plants evolving the ability to flower and spread seeds in farther environments. Understanding the vascularization, specialized structures, and reproduction of plants are important in order to identify and observe plants and their evolution over time. The purpose of this lab is to understand the characteristics and diversity of plants as well as the function of fungus.
Materials/Methods
Part I: Collecting plant samples from transect
1. Obtain leaf litter sample from a site at transect
2. Dig into the crumbly top layer of soil and plant matter in area with soft soil and dead leaves covering
3. Place approximately 500 g of dug up matter into plastic bag
4. Take representative samples from five plants on transect (without damaging plants) with as much diversity as possible
5. Find any seeds, pine cones, flowers etc from the five plants for assistance in identification
6. Note seeds, monocots and dicots, vascularization, and shape size and cluster arrangement of leaves
7. Compare samples to libraries in lab to identify
Part II:Observing Fungi
1. Observe transect fungi samples under dissecting microscope
2. Identify whether saprobe, parasite, or zygomycota
Part III: Berlese Funnel for Collecting Invertebrates
Figure 1: Shows the location of each plant sample taken from transect
1. Pour 25 mL of 50:50 Ethanol/water solution into flask
2. Fit screening material into the bottom of the funnel
3. Tape sides of screen so that leaf litter does not fall into preservative
4. Place funnel into the neck of flask
5. Add leaf litter collected at transect to the top of the funnel
6. Place under lighted 40 watt lamp about 1-2 inches from the top of the leaf sample
7. Let sit for a week
Figure 2: Berlese Funnel diagram as depicted in the Bio 210 Lab Instructions
Raw Data/Observations
Part I:Collecting plant samples from transect
Figure 3: Data observations of five plant leaf samples collected on American University 20 ft x 20 ft transect
Part II:Observing Fungi
Figure 4: Bread mold depicted by Google as well as observed drawing from under dissecting microscope. Fungus is saprobes.
Conclusion
Based off of the five sample plants taken from an American University 20 ft x 20 ft transect, it was observed that the plant life on the transect is made up of mostly angiosperms both flowering plants/bushes and flowering weeds. We observed surface nourishing webbed vascularization in the broadleaf Plantains, the unidentified sample, and the Red Twig dogwood leaves, but noticed that grass and cat tails do not have vascularization and have linear veins like lines on their leaves. These come directly from the roots in the ground which provide water and nutrients. We also identified some monocot seeds and dicot seeds lying around the area which likely came from the plants on the transect, deposited by birds, runoff, or wind. There are no trees on the transect, however, that does not mean that leaves from trees nearby have not blown on to the transect or been carried with runoff and erosion to the transect. Since the transect is at a downhill location surrounding a drain, it is no surprise that the flowering plants, the angiosperms, are ones that survive in environments with high levels of moisture. The angiosperms identified on the transect were the Cat tail, grass, broadleaf plantain and the Red Twig Dogwood. The unidentified plant appears as if it could be a plantain as well as there are many strains, however, searches were inconclusive as it looks like a generic weed. Because of all of the runoff from rain and melted snow it is no surprising that there are weeds on the transect. It is also not surprising that there was fungus found growing on the agar plates grown from the Hay Infusion cultures. With the amount of movement that comes through the transect it is expected that there would be a large amount of fungi present. In observing fungus in lab it is interesting observe common fungus on a more magnified scale. Common fungus decomposing a piece of bread, was magnified to identify spores and accumulation. In conclusion, the transect environment is supportive of angiosperms, is likely not suitable for large trees, but has exposure/plant influence from surrounding areas due to runoff/erosion, human traffic, and animal transfer. In the future it will be interesting to observe the invertebrates that survive in the damp environment on this transect.
CMP
2/16/14
Introduction/Purpose
Traditionally, classifying microorganisms is based off of cell morphology. Scientists use staining techniques in order to observe unicellular organisms under the microscope. There are three basic bacterial shapes: bacillus, coccus, and spirillum. Bacillus is rod-shaped, coccus is spherical, and spirillum is a twisted spiral. While staining helps see the shape of the cell, but it can also define the structural characteristics of the cell wall. The Gram Stain is most common, and it indicates whether a cell has a large layer of peptidoglycan in their cell wall, gram positive, while gram negative cells have little peptidoglycan. This lab is designed to observe and identify different structures of bacteria that was grown using our Hay Infusion cultures. It is predicted that there will be all different types of bacteria that can be found on the transect. There will be variation between the structure, gram stain, and antibiotic resistance. Tetracycline is a antibiotic that is designed to prevent the growth and spread of bacteria. While quantity will likely be way less, it is predicted that there will even be bacterial growth on the plates treated with Tetracycline.
Materials/Methods
Part I: Bacteria Cell Morphology
1. Obtain prepared slides with known types of bacteria
2. Observe samples using 10x and 40x objective
3. Make 3 wet mounts using bacteria grown on agar plates using Hay Infusion sample
4. Observe wet mount under 10x and 40x
Part II: Gram Staining
1. Use sterilized loop to transfer part of bacteria colony onto slide
2. Heat fix the air dried slide by passing it through a flame three times with the bacteria smear side up
3. Cover smear with crystal violet for 1 minute
4. Rinse the stain
5. Cover the smear with Gram’s iodine mordant for 1 minute, rinse gently
6. Decolorize by flooding smear with 95% alcohol for 10-20 seconds
7. Rinse gently
8. Cover smear with safranin for 20-30 seconds
9. Rinse
10. Blot excess water with paper towel
11. Observe slide under 40x objective
Part III: PCR Preparation for DNA Sequence Identification
1. In separate tubes, transfer two colonies to 100 uL of water in a sterile tube
2. Incubate at 100oC for 10 minutes
3. Centrifuge
4. Add 5 uL to PRC tube and incubate
Raw Data/Observations
Hay Infusion Observation
• Less water
• Clear film and algae
• Sour sewage smell is less potent
• Crusty edges
• Less milky/cloudy
• Brown
• Sediment
Bacteria Cell Morphology and Gram Staining Observations
Figure 1: Shows the bacteria and fungus cultured from the Hay Infusion samples on plain agar and tetracycline treated plates.
Colonies were much more abundant and larger on the agar plates not treated with the antibiotic Tertacycline. There were only 3 colonies to choose from on the Tetracycline plate, and an abundance on the lain nutrient agar plates.
PCR Observation for Lab 4
Neither colony 1 or 3 were sent for sequencing
Conclusion
Based on the observations made in this lab, all types ob bacteria can be expected to be found almost anywhere. When observing the bacterial colonies under the microscope, there was evidence of rod shaped, spiral, and spherical bacterial. There was evidence of both gram negative and gram positive bacteria as well, and bacteria that is antibiotic resistant. This shows that different bacteria coexists in environments just like the protists and organisms we have studied in past labs. The presence of this bacteria is likely naturally occurring as well as introduced from car pollutants, human interaction, and runoff. It will be interesting to study life that is surviving in the same environment as the bacteria found on the transect.
CMP
2/9/14
Lab 2
Introduction/Purpose
There are two groups of unicellular eukaryotes, algae and protists. Algae use photosynthesis, harnessing energy from the sun for nourishment, while protists consume nutrients to survive. The cohabitation of algae and protists only accounts for a fraction of the life and influence that exist in an environment, however, since an abundance of algae and protists survive hidden from the naked eye, it is important to identify which organisms thrive in which environments. This lab is designed to understand the characteristics of algae and protists. It is also designed to practice using a Dichotomous Key to identify algae and protests thriving on a 20 ft x 20 ft transect of land on American University’s campus.
Materials/Methods
Part I: Using a Dichotomous Key
1. Make wet mount of known sample
2. Observe size, shape, movement, and color of a single cell organism in sample under 10x and 40x
3. Choose accurate answer for question 1 on the Dichotomous Key
4. Move to where that choice directs you to go
5. Continue follow the key until organism is identified
6. Compare organism to the picture provided
7. Repeat with a second organism
Part II: Hay Infusion Culture Observations
1. Make wet mount of 3 samples taken from different locations in the Hay Infusion culture
2. Observe size, shape, movement, and color of a single cell organism in sample under 4x and 10x
3. Choose accurate answer for question 1 on the Dichotomous Key
4. Move to where that choice directs you to go
5. Continue follow the key until organism is identified
6. Compare organism to the picture provided
7. Repeat with a second organism
Part III: Preparing and Plating Serial Dilutions
1. Obtain 4 tubes of 10 mL sterile broth
2. Obtain 4 nutrient agar and 4 nutrient agar plus Tetracycline plates
3. Using a micropipette, take 100 uL of the hay infusion mixture and add to the 10 mL of broth in Tube 2 (1:100 dilution)
4. Take 100 uL of the mixture in Tube 2 and add to the 10 mL of broth to Tube 4 (1:10,000 dilution)
5. Repeat two more tomes to make 1:1,000,000 dilution and 1:100,000,000 dilution in Tube 6 and Tube 8, respectively
6. Take 100 uL from Tube 2 and place on surface of nutrient agar plate 10-2, spread sample on the plate
7. Take 100 uL from Tube 2 and place on surface of nutrient agar plate plus Tetracycline, spread sample on the plate
8. Repeat with Tubes 4, 6, 8 excluding Tetracycline plate for tube 8
9. Incubate plates at room temperature for one week
Raw Data/Observations
Part I: Using a Dichotomous Key
Table 1: Observations of known organisms at 10x and 40x
Part II: Hay Infusion Culture Observations
Image 1: Shows transect with the location of Hay Infusion culture sample noted with a red arrow.
Image 2: Shows the Hay Infusion culture of 20 ft x 20 ft transect sample after 1 week incubation. Smells sour like sewage, has a film on the top, with yellow/brown water and crusty edges. There is sediment on the bottom, floating greens, and the water is cloudy but see through. It appears fuzzy.
Table 2: Observations and identification of unknown organisms found in hay infusion culture
Part III: Preparing and Plating Serial Dilutions
Conclusion
Based on the initial observations of the hay fusion algae and protists, it is evident that there are many protists, and bacteria present on the transect. It appears that there are multiple variations of algae and protists coexisting in this ecosystem. For example, Peranema as seen in Table 2, it is able to acquire and use energy through nutrients in its environment. It is unicell ular with a nucleus and self replicates. Since it eats nutrients, it has the ability to evolve, selecting for traits such as longer eating flagellum.
Some of the organisms reside near plants where they can survive off of nutrients present in the sample while others are found where they can photosynthesize with exposure to sunlight. If the hay infusion were to observed for another two months, it is possible that new variations of organisms would evolve, and it is possible that some would diminish due to selective pressures such as lack of sunlight for photosynthesizing organisms or exhaustion of nutrients for protists. Although the hay infusion will not be observed further, it will be interesting observing the bacteria and fungus present when observing the dilutions on the agar plates. It will also be interesting to see which bacteria, if any are tetracycline resistant which will be evident by growth on the tetracycline plates. Since there are large amounts of algae and protists, it is likely that there will be large amounts of bacteria found at the transect. Large amounts of protists and algae are likely due to the runoff and erosion that crosses the transect, the human interaction with the transect by way of pedestrians on the sidewalk, and car exhaust, ect. These influences will probably cause high levels of bacteria, which will be observed in future labs.
CMP
2/6/14, lab 1 notes
Great job! Start working on building a map of your transect to detail your land and where your samples are taken from. We will talk about this more Wednesday
AP
1/31/2014
Lab 1
Introduction/Purpose
There are millions of identified and unidentified forms of life on the planet. Each form of life has a specific set of requirements that when put together forms their niche. Usually there is more than one group of the same species living in the same area with nonliving components, an ecosystem, however, each ecosystem is reliant on large amounts of biodiversity due to the number and kinds of species present. The purpose of this lab is to study how different organisms and species interrelate with each other and their environment in an ecosystem. This lab is designed to observe and understand the balance, complexities, and interactions of the organisms inhabiting a 20 ft x 20 ft transect on American University’s campus. It is predicted that the transect will exhibit less biodiversity than expected from a plot of similar nature due to the artificial origin of the land. Further, there will likely be more similar organisms of the same species rather than different species than expected of a plot of land that occurred naturally. However, due to human exposure there is still likely to be a large variety of organisms inhabiting the transect.
Materials/Methods
Part I: The Volvicine Line
1. Create wet mounts of Chlamydomonas and Gonium 2. Create Depression Slide of Volvox 3. Observe under the microscope
Part II: Defining a Niche at AU
1. Observe 20 ft x 20 ft transect on American University campus 2. Identify abiotic and biotic factors present on transect (detailed in the Initial observations section) 3. Collect 50 mL soil and ground vegetation sample 4. Make a Hay Infusion Culture by following the steps outlined below: a. Mix 10-12 grams of transect soil sample with 500 mL of Deer Park water b. Add 0.1 g dried milk c. Mix for 10 seconds d. Leave jar uncovered for future observation
Raw Data
Table 1: Evolutionary Specialization of Members of the Volvocine Line
Chlamydomonas Gonium Volvox
Number of Cells (one field of view) 35; 1 cell, 3 in field of view; 6 daughter cells, 1 in field of view
Colony Size 4 ocular ticks @ 40x = 10 um; 5 ocular ticks @40 x = 12.5 um; 35 ocular ticks @ 10x = 350 um
Functional Specialization Moves quickly, visible pyrenoid; Moves quickly; Falgellum
Reproductive Specialization Isogamy; Isogamy; Oogamy
Initial observations of 20 ft x 20 ft transect:
Location: bordered by Massachusetts Ave, campus entrance, and sidewalk behind Kogod and across the street from the campus arts center. Topography: downhill, transect has slight slant itself
Abiotic Factors:
• Light – Sun
• Air – completely exposed to air with exposure to motor exhaust and human breath as well as open air
• Water – drainage due to downhill orientation
• Soil/earth – soil, dead leaves, erosion
• Minerals – rocks, sand, boulders, sidewalk
• Other – litter, cigarette butts, human spit, chewing gum attracts animals
Biotic Factors:
• Plants – tall grass, cat tails, grass, weeds, moss, algae
• Animals – worms, birds, humans, squirrels
• Bacteria – everywhere
• Fungus – on rocks, in the dirt
• Protists – everywhere
Conclusion Based off of the initial observations of the transect, it is likely that there are many protists, bacteria, and fungi present in the transect. It is going to be interesting observing the transect over the semester due to the large amounts of snow that has already fallen this year and the runoff and erosion, caused by melted snow, that will impact the habitat. In the furture it would be interesting to observe human interaction with the transect by way of pedestrians on the sidewalk, car exhaust, ect.
CMP
1/22/2014
I successfully entered text, this will work!!
CMP